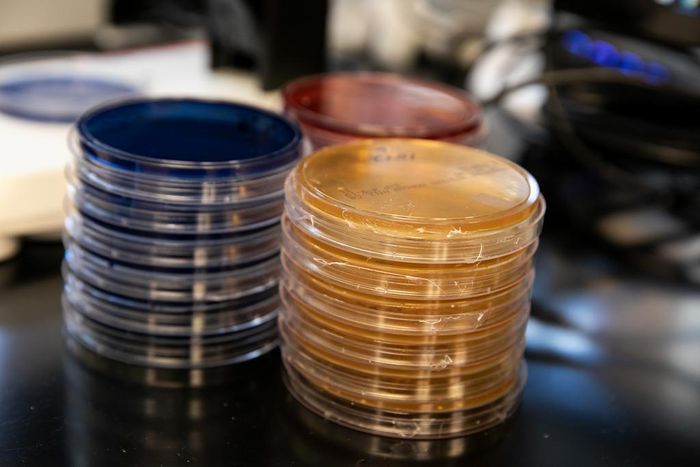
Fecal Donation Tied to Death of a Patient

Fecal donation tied to death of a patient
)
Two patients contracted severe infections, and one of them died, from fecal transplants that contained drug-resistant bacteria, the Food and Drug Administration reported Thursday.
As a result, the agency is halting a number of clinical trials until the researchers conducting them can demonstrate that they have procedures in place to screen donated stool for dangerous organisms, said Dr. Peter Marks, director of the agency’s Center for Biologics Evaluation and Research. He did not specify how many trials would be suspended but said it was “not just a few.”
Fecal transplants have come into increasing use to treat severe intestinal disorders, particularly an infection caused by a bacterium called Clostridium difficile, which can be deadly and tends to occur in hospitalized patients who have been heavily treated with antibiotics. The idea behind the transplants is to use stool from a healthy donor to restore the normal balance of bacteria and other organisms in the intestine, the microbiome.
In some cases, the transplants have worked quickly and saved the lives of patients who were wasting away with uncontrollable diarrhea. But the procedure is not approved by the FDA and is considered experimental.
In the newly reported cases, both patients’ immune systems were already compromised at the time of the transplant, the FDA said. The agency would not explain why they were immunocompromised, why they were given the transplants, who performed the procedures or when or where the cases occurred.
Both transplants came from the same donor’s fecal matter. The report does not state whether the fecal material was given in liquid form as an infusion into the digestive tract or swallowed as pills.
Other samples from the same donor were tested after the patients got sick. The samples were found to harbor the same dangerous germs found in the patients, known as multi-drug-resistant organisms. They were E. coli bacteria that produced an enzyme called extended-spectrum beta-lactamase, which makes them resistant to multiple antibiotics. The stool had not been tested for the germs before being given to the patients.
The FDA on Thursday issued a warning to researchers that stool from donors in studies of fecal transplantation should be screened for drug-resistant microbes and not used if those were present. It is also warning patients that the procedure can be risky, is not approved by the agency and should be used only as a last resort when C. difficile does not respond to standard treatments.
Marks said the agency was trying to strike a balance between giving patients who need the treatment access to it while also establishing safeguards to protect them from infection. In a statement, he said, “While we support this area of scientific discovery, it’s important to note that fecal microbiota for transplantation does not come without risk.”
The patients received treatment as part of a clinical trial, and the researchers conducting the trial reported the cases as adverse events to the FDA, which they were required to do. But the rules governing this kind of experiment prohibit the FDA from revealing details about the treatment or who provided it.
This article originally appeared in The New York Times.
)
)
)
)
)
)